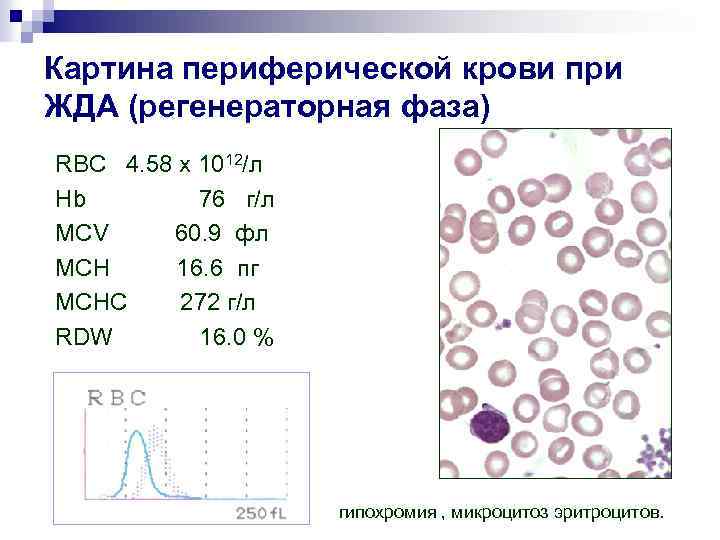
Картина периферической крови при ЖДА (регенераторная фаза) RBC 4. 58 x 1012/л Hb 76
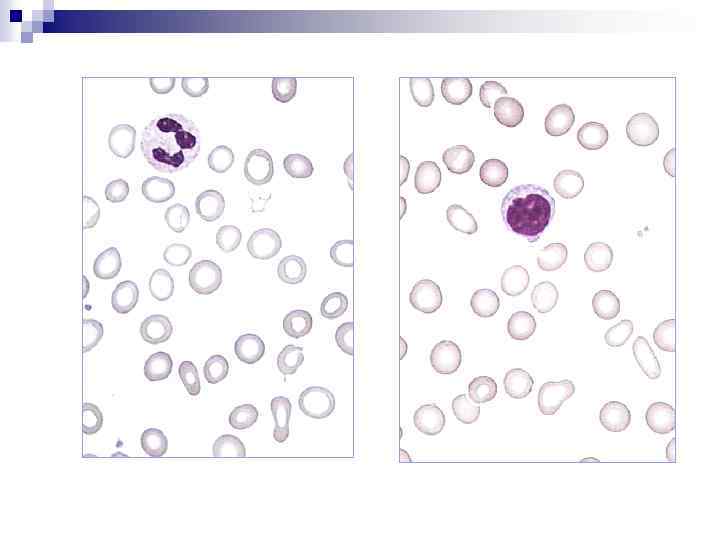
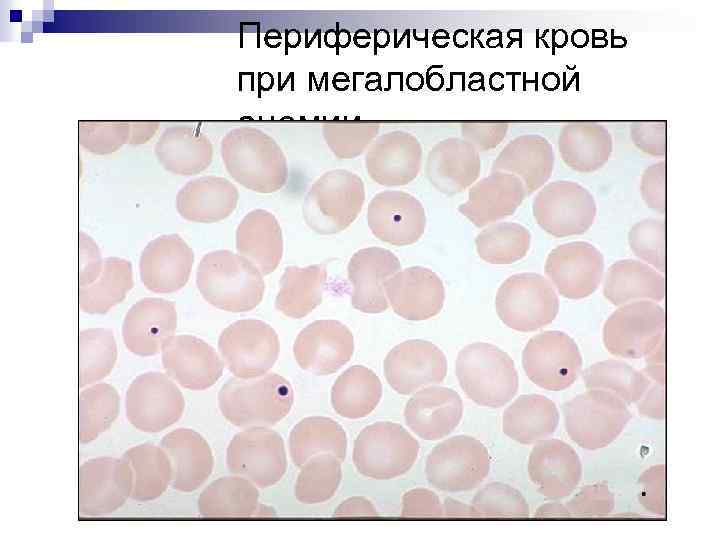
Периферическая кровь при мегалобластной анемии
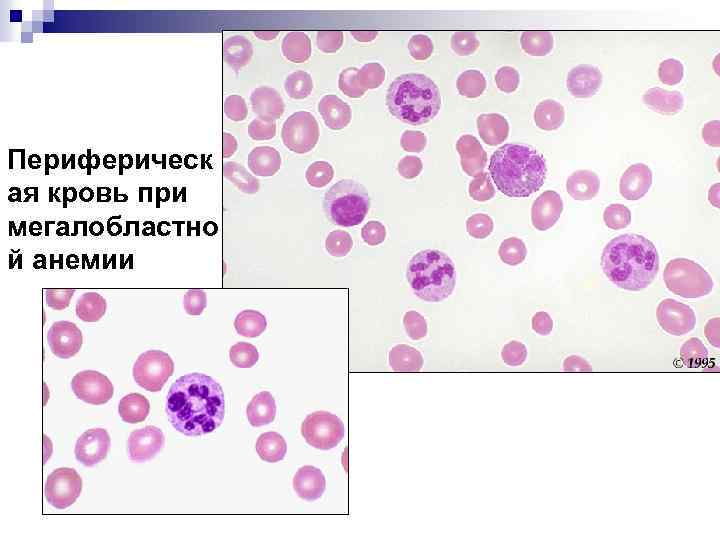
Периферическ ая кровь при мегалобластно й анемии
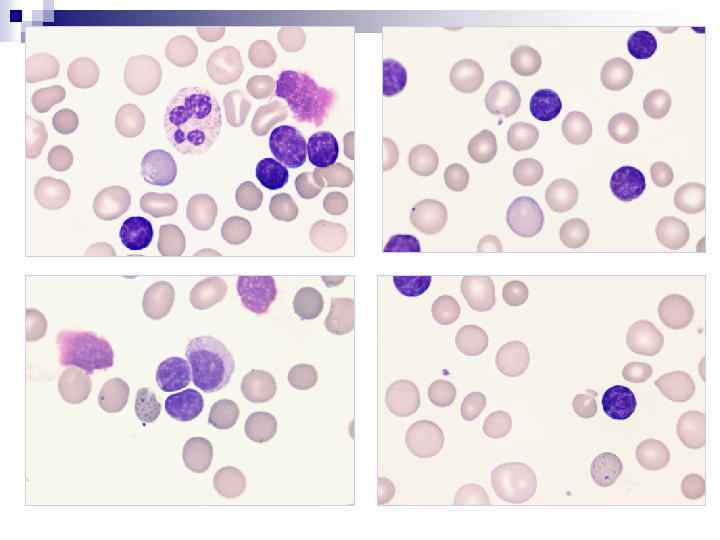
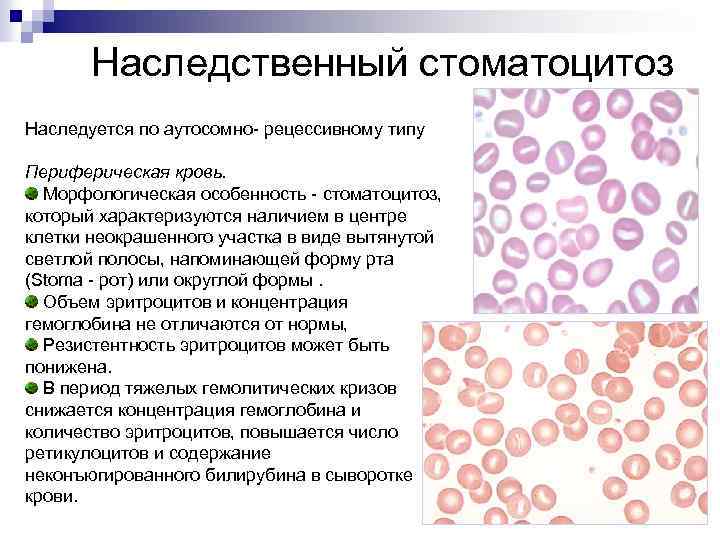
Наследственный стоматоцитоз Наследуется по аутосомно- рецессивному типу Периферическая кровь. Морфологическая особенность - стоматоцитоз, который

Анемии лекция МПФ.ppt
- Количество слайдов: 65

Лабораторная диагностика анемий

Кинетика эритрона.

Параметры, характеризующие красную кровь.

Параметры, характеризующие красную кровь.

Нормальная RBC-гистограмма

Ретикулоциты – костномозговые предшественники эритроцитов. Нормальное содержание в периферической крови – 2 -10‰ (0, 2 -1, 0%)

Исследование ретикулоцитов используется для: n n n детекции нарушения регенераторной способности костного мозга при дефиците железа, витаминов В 12, В 6, фолатов, меди и мониторинга соответствующей терапии; оценки активности эритропоэза при состояниях, сопровождающихся гемолизом или кровопотерей; диагностики апластической анемии; оценки состояния эритропоэза на фоне лечения эритропоэтином; оценки способности костного мозга к регенерации после цитостатической терапии и трансплантации костного мозга; допингового контроля у спортсменов (прием ЭПО – Ret>2, 4%, Ht>47% )

Под термином "анемия" понимают состояние, характеризующееся снижением уровня гемоглобина в единице объема крови. Количество эритроцитов также может быть понижено. . Диагностическиt критерии анемии: у мужчин у женщин RBC < 4, 0 млн/мкл, Hb < 130 г/л, Ht < 40 % RBC <3, 8 млн/мкл, Hb < 120 г/л, Ht < 36 %

Разделение анемий по патогенетическому принципу. Анемии вследствие нарушения эритропоэза: n n n ЖДА, анемии связанные с нарушением синтеза и утилизации порфиринов, ) мегалобластные анемии апластические анемии Анемии вследствие повышенного разрушения эритроцитов (гемолитические анемии) Анемии, обусловленные кровопотерей (острые постгеморрагические анемии)

Снижение Hb MCV менее 80 fl MCH менее 26 пг MCHC менее 320 г/л RDW норма или увеличен Микроцитарные гипохромные анемии ЖДА Нарушение синтеза и утилизации порфиринов, Гетерозиг. талассемия и др. MCV в пределах нормы MCHC в пределах нормы RDW обычно в пределах нормы MCV более 100 fl MCH более 32 пг MCHC в пределах нормы RDW увеличен Нормоцитарные Нормохромные анемии Макроцитарные нормо- или гиперхромные анемии Анемии при заболеваниях почек Гипопластические анемии Острая постгеморрагическая анемия, АХЗ В 12 -дефицитная анемии Фолиеводефицитная анемия Анемия при хронических заболеваниях печени, АИГА

Гипохромные микроцитарные анемии

Железодефицитная анемия - самое распространенное заболевание во всем мире. По данным ВОЗ зарегистрировано около 1 млрд человек страдающих ЖДА Железо — облигатный биометалл: метаболизм; пролиферация. Распределение железа железосвязывающие белки свободное железо инициация цепных реакций образования свободных радикалов: 1. Перекисное окисление липидов биомембран. 2. Токсическое повреждение белков. 3. Токсическое повреждение клеточного генома

Распределение железа в организме

Обмен железа в организме

Транспорт железа Трансферрин n Транспортный белок ( -1 -глобулин), гликопротеин, 2 центра связывания, 88 к. Да. n Переносит Fe из ЖКТ к эритрокариоцитам и в тканевые депо (печень и др. ). n Нормальный уровень: 2, 6 0, 05 г/л. n Насыщение трансферрина железом: 3075%. n Поступает в клетку путем эндоцитоза: захват клеткой комплекса Fe-трансферрин.

Депонирование железа: ферритин и гемосидерин Ферритин (500 к. Да; содержит 15 -20% от общего Fe) n Внутриклеточный протеин — показатель величины запасов железа: кратковременное и длительное депонирование Fe 2+ в тканях. • Основные источники n Показатель степени сывороточного ферритина: острофазового ответа и 1. Моноциты крови деструктивных процессов: 2. Купферовские повышение продукции клетки печени ферритина (инфекция, 3. Макрофаги иммунные комплексы, селезенки. опухоли).

n Этиология железодефицитной анемии Кровопотери : - менструальные кровопотери, беременность, роды, лактация; - кровопотери из желудочно-кишечного тракта : язвенные поражения, опухоли, полипы, дивертикулез, геморрой, глистные инвазии (анкилостомидоз); - кровопотери в замкнутые полости с нарушением реутилизации железа: эндометриоз, легочный сидероз, гломические опухоли; n Донорство Нарушение всасывания (хронический энтерит, резекция n n Алиментарный фактор (растительно-молочная диета) Повышенная потребность в железе: ранний детский n У детей n тонкой кишки, дисбактериоз, лямблиоз) возраст, подростковый период, беременность, лактация - недоношенность; - многоплодная беременность; - поздний прикорм

Клиника ЖДА n Скрытый (латентный )дефицит железа СИДЕРОПЕНИЧЕСКИЙ СИНДРОМ: РЕЗКОЕ ВЫПАДЕНИЕ, СУХОСТЬ И ЛОМКОСТЬ ВОЛОС, РАННЯЯ СЕДИНА, УПЛОЩЕНИЕ НОГТЕЙ, ИХ ЛОМКОСТЬ, ТРЕЩИНЫ, ПОПЕРЕЧНЫЕ БОРОЗДЫ, СУХОСТЬ КОЖИ, ГИПЕРКЕРАТОЗ, БОЛЕЗНЕННЫЕ НЕЗАЖИВАЮЩИЕ ТРЕЩИНЫ В УГЛАХ РТА, НА ЯЗЫКЕ, НА ПАЛЬЦАХ РУК И НОГ, ПЯТКАХ ИЗВРАЩЕНИЯ ВКУСОВЫХ И ОБОНЯТЕЛЬНЫХ ПРИСТРАСТИЙ ЧАСТЫЕ ИНФЕКЦИИ, УВЕЛИЧЕНИЕ АДЕНОИДОВ НАРУШЕНИЯ ГЛОТАНИЯ, МЫШЕЧНАЯ СЛАБОСТЬ, СЛАБОСТЬ СФИНКТЕРОВ (НЕУДЕРЖАНИЕ МОЧИ ПРИ КАШЛЕ, СМЕХЕ) ЛАБОРАТОРНЫЕ ПОКАЗАТЕЛИ скрытого дефицита железа: Hb, RBC, MCV, MCHC, RDW - НОРМА, СЫВОРОТОЧНОЕ ЖЕЛЕЗО – СНИЖЕНО ИЛИ НОРМА ТРАНСФЕРРИН - НОРМА ФЕРРИТИН – СНИЖЕН Растворимые рецепторы к трансферрину - -повышены

Собственно железодефицитная анемия АНЕМИЧЕСКИЙ СИНДРОМ: слабость, головокружение, сердцебиение, одышка, обмороки СИДЕРОПЕНИЧЕСКИЕ СИНДРОМЫ прогрессируют

Картина периферической крови при ЖДА n n n n n количество эритроцитов в регенераторную стадию обычно в пределах нормы, в гипорегенераторную – снижено; гемоглобин снижен, МСН (менее 27 пг) – гипохромия (ц. п. <0, 85), МСНС (менее 310 г/л), МСV (менее 78 фл) - микроцитоз. RDW может оставаться нормальным или незначительно повышенным (признак анизоцитоза). ретикулоциты в пределах нормы, либо несколько повышено при наличии кровотечения. лейкоциты и тромбоциты - в пределах нормы. При хронических кровотечениях может наблюдаться небольшой тромбоцитоз либо тромбоцитопения. СОЭ - чаще норма.

Периферическая кровь при ЖДА Морфологическим признаком железодефицитной анемии является гипохромия эритроцитов и анизоцитоз со склонностью к микроцитозу
Картина периферической крови при ЖДА (регенераторная фаза) RBC 4. 58 x 1012/л Hb 76 г/л MCV 60. 9 фл MCH 16. 6 пг MCHC 272 г/л RDW 16. 0 % гипохромия , микроцитоз эритроцитов.

Б-ой А. , 42 года, скрытая кровопотеря в результате язвы 12 -перстной кишки. Анализ периферической крови б-го А. : WBC – 5, 9 x 109/л, RBC – 3, 45 x 1012/л, Hb – 54 г/л, Ht – 19, 1%, MCV – 55, 4 фл, MCH – 15, 7 пг, MCHC - 283 г/л, RDW – 25, 0%, PLT – 151, 0 x 109/л Клинический случай.

Больная Б. , 35 лет, в анамнезе эндометриоз. Жалобы на меноррагии. Анализ периферической крови б-ой Б. : WBC – 3, 9 x 109/л, RBC – 2, 72 x 1012/л, Hb – 48 г/л, Ht – 16, 6%, MCV – 61, 0 фл, MCH – 17, 6 пг, MCHC - 289 г/л, RDW – 28, 1%, PLT – 131, 0 x 109/л


СОВРЕМЕННЫЕ ПРИНЦИПЫ ЛЕЧЕНИЯ ЖДА. n n n Устранение причины кровопотери; Невозможность вылечить продуктами питания; Отказ от переливания крови; Использование только препаратов железа в адекватной дозе : 100 -150 мг/сутки; Пероральное применение препаратов железа (парентеральное только при доказанном нарушении всасывания) n Длительное применение препаратов (до восстановления депо)

ЖДА При ЖДА отмечается снижение показателя CHr (или RET-Y) отражающего концентрацию гемоглобина в ретикулоцитах. Значения RET-Y < 171, RBC-Y < 168, 7, CHr < 28 пг являются индикаторами железодефицитного эритропоэза. Процент гипохромных эритроцитов (% Hypo) более 10% указывает также на железодефицитное состояние. Для функционального дефицита железа значение cut-off % Hypo составляет более 5%. • оценка эффективности терапии препаратами железа

Динамика ретикулоцитарных показателей при железодефицитной анемии на фоне приема препаратов железа Показатели 7 день 18 день RET% 1, 43 ± 0, 4 3, 21 ± 1, 1 RET# 0, 05 ± 0, 02 0, 1 ± 0, 01 MRV (фл) 112, 6 ± 9, 2 121, 3 ± 10, 1 IRF 0, 36 ± 0, 07 0, 62 ± 0, 09

Нормохромные нормоцитарные анемии

Апластическая анемия WBC RBC HGB HCT MCV MCHC PLT RDW-CV 2, 13 3, 09 10, 4 30, 9 100, 0 33, 7 10 13, 8 103/мл 106/мл г/дл % фл пг г/дл 103/мл % RET# IRF 0, 7 0, 22 4, 5 · Ретикулоцитопения является одним из критериев диагностики тяжелой апластической анемии. · %% 109/л %

Макроцитарные анемии

Hb↓, RBC↓ MCV-↑, MCH-↑ , MCHC-N, RDW- ↑

Мегалобластическое кроветворение наблюдается: n n n Дефиците витамина В 12 Дефиците фолиевой кислоты Острый эритромиелоз Миелодиспластический синдром Применение цитостатиков-антиметаболитов (метотрексат, 6 -меркаптопурин, АРА-С и др. ) n Оротовая ацидурия ( у детей - наследственный дефицит ферментов, участвующих в метаболизме оротовой кислоты)

В 12 - дефицитная анемия Витамин В 12 участвует в : 1. Синтезе ДНК ( поэтому при его недостатке особенно страдают интенсивно пролиферирующие ткани - кроветворная и эпителий кишечника) 2. Преобразовании метилмалоновой кислоты (накопление последней токсично для нервной ткани)

Причины дефицита витамина В-12. n Нарушение всасывания - отсутствие внутреннего фактора Касла( атрофический гастрит, резекция желудка, облучение желудка) - поражение тонкого кишечника (энтерит, дисбактериоз, резекция тощей кишки, целиакия и т. д. ) n n Недостаточное поступление с пищей Конкурентное поглощение (широкий лентец, лямблиоз, патологическая микрофлора при наличии дивертикулеза или «слепой петли» ) n Повышенная утилизация витамина В 12 (злокачественные новообразования, гипертиреоидизм)

Клиническкая картина дефицита витамина В 12. Кроветворение: АНЕМИЯ, ЛЕЙКОПЕНИЯ, ТРОМБОЦИТОПЕНИЯ В РЕЗУЛЬТАТЕ МЕГАЛОБЛАСТИЧЕСКОГО ГЕМОПОЭЗА, ЖЕЛТУШНОСТЬ КОЖНЫХ ПОКРОВОВ, ГИПЕРБИЛИРУБИНЕМИЯ, УВЕЛИЧЕНИЕ ПЕЧЕНИ ВСЛЕДСТВИЕ НЕЭФФЕКТИВНОГО ЭРИТРОПОЭЗА n Желудочно-кишечный тракт: ГЛОССИТ, СНИЖЕНИЕ СЕКРЕЦИИ, ОТСУТСТВИЕ АППЕТИТА, ДИСПЕПСИЯ, ПРИВОДЯЩАЯ К ПОТЕРЕ ВЕСА n Нервная система: ПАРЕСТЕЗИИ, ОЩУЩЕНИЕ «ВАТНЫХ НОГ» , АТАКСИЧЕСКАЯ (СПАСТИЧЕСКАЯ) ПОХОДКА, ПАРАПАРЕЗЫ И ПАРАПЛЕГИИ, РАДИКУЛЯРНЫЕ БОЛИ, ПСИХОЗЫ. n

Лабораторная диагностика В 12 -дефицитной анемии. Клинический анализ крови анемия, лейкопения, тромбоцитопения; ретикулоциты ниже 1, 2%; гиперхромия, макроцитоз эритроцитов (MCV более 100 fl, MCH более 32 пг, n увеличение RDW ); ускоренное СОЭ. Мазок крови макро-, мегалоцитоз, шизоцитоз; базофильная пунктация эритроцитов, тельца Жолли, кольца Кебота в эритроцитах, гиперсегментация ядер нейтрофилов (более 5 сегментов) n

Анализ периферической крови при В 12 -дефицитной анемии 12 RBC 2. 45 x 10 /л Hb 100 г/л MCV 123. 7 fl MCH 40. 8 пг MCHC 330 г/л RDW 18. 3 % макроцитоз, гиперхромия эритроцитов, встречаются эритроциты с базофильной пунктацией

Периферическая кровь при мегалобластной анемии
Периферическая кровь при мегалобластной анемии
Периферическ ая кровь при мегалобластно й анемии

Костный мозг при В 12 -дефицитной анемии Костный мозг гиперплазия эритроидного ростка, мегалобластический эритропоэз, причудливые ядра нормобластов, кариорексис, дистрофические явления, гигантизм и уродливость клеток гранулоцитарного ряда n Исследование концентрации витамина В 12 в сыворотке крови вит. В 12 - ниже 148 пмоль/л у больных до 60 лет вит. В 12 - ниже 80 пмоль/л у больных старше 60 лет n

Фолиеводефицитная анемия • Запасы в организме – 5 -10 мг. • При отсутствии поступления – истощаются через 34 месяца • Суточная потребность – 50 -100 мкг. • 50% фолатов разрушается при термической обработке пищи. • В крови связывается с различными белками ( 2 -макроглобулином, альбумином) • Запасается в печени в виде полиглутаматов • Участвует в процессах пролиферации клеток (синтез пуриновых оснований)

Причины развития фолиеводефицитной анемии • Снижение содержания в пище (алкоголизм, голодание, длительная термическая обработка пищи) • Нарушение всасывания (хр. энтерокаллит, резекция тонкой кишки, диабетическая энтеропатия, целиакия, амилоидоз и т. д. ) • Повышенная потребность (беременность; гемолотические анемии, лейкозы, рак, туберкулез, гипертиреоз) • Уменьшение запасов в печени (алкоголизм, цирроз, гепатоцеллюлярный рак) • Прием лекарственных препаратов (цитостатики, противосудорожные, противотуберкулезные препараты)

Гемолитические анемии

Внутриклеточный гемолиз ПЕЧЕНЬ Билирубин Биливердин (восстановление NADFH) Глобин (расщепление до аминок-т) Билирубин непрямой + альбумин КРОВОТОК Билирубин + Глюкуроновая кислота Прямой билирубин V. porta Уробилиноген Вердоглобин (отщепление Fe 3+и глобина) Met. Hb МФ СЕЛЕЗЕНКИ Почки Уробилиноиды мочи Стеркобилиноген Стеркобилин КИШЕЧНИК

Внутриклеточный гемолиз Анемия Увеличение селезенки Нормохромная нормоцитарная (MCV=N, MCH=N, MCHC=N) При наследственных гемолитических анемиях – сфероцитоз, овалоцитоз, дрепаноцитоз (серповидные эритроциты), мишеневидные эритроциты Гиперплазия Ретикулоцитоз эритроидного ростка костного мозга Повышен непрямой билирубин в Желтуха крови Увеличение Увеличен стеркобилин кала печени Увеличен уробилин мочи

Патологический внутриклеточный гемолиз возникает при: n n n наследственной неполноценности мембраны эритроцита (эритроцитопатии) нарушении синтеза гемоглобина (гемоглобинопатии) нарушении синтеза ферментов – энзимопатии (дефицит ПК, тяжелая гипофосфатемия, дефицит пиримидин-5 -нуклеотидазы) избыточном количестве эритроцитов (физиологическая желтуха, эритробластоз новорожденного, эритремия – при количестве эритроцитов более 6 -7 x 1012/л). приобретенных аутоиммунных гемолитических анемиях (с агглютининами)

Внутрисосудистый гемолиз Фагоцитоз Hb Гемолиз в почки Hb, задержанный в канальцах Гаптоглобин Hb связывается. Гем катаболизируется Альбумин Гемопексин Диссоциация на глобин и гем Hb, выделяемый с мочой Гем связывается Ретикулоэндотелиальная система Эритроциты Hb окислятся в Met. Hb Фагоцитоз

Внутрисосудистый гемолиз Анемия Нормохромная нормоцитарная (MCV=N, MCHC=N) Морфология эритроцитов без особенностей Гиперплазия эритроидного ростка костного мозга Ретикулоцитоз Гемоглобинурия Моча темно-красная, черная Белок мочи значительно повышен Проба на кровь резко положительна В осадке эритроцитов нет, гемосидерин Свободный гемоглобин плазмы Более 3 мг/100 мл

Патологический внутрисосудистый гемолиз возникат при: n n n токсических, механических, радиационных, инфекционных повреждениях мембраны эритроцитов, пароксизмальной ночной гемоглобинурии, эритроцитарных энзимопатиях (дефицит Г 6 ФДГ) паразитозах, в частности, малярии, приобретенных аутоиммунных гемолитических анемиях (гемолизины), пострансфузионных осложнениях, несовместимости по групповому или резус-фактору, переливании донорской крови с высоким титром антиэритроцитарных антител и других заболеваниях.

Классификация ГА I. НАСЛЕДСТВЕННЫЕ Гемолитические Анемии 1. ГА, связанные с нарушением мембраны эритроцитов (эритроцитопатии) n Наследственный микросфероцитоз (б-нь Минковского-Шоффара) n Наследственный элиптоцитоз (овалоцитоз) n Наследственный стоматоцитоз n Наследственная - -липопротеинемия (акантоцитоз) 2. Гемоглобинопатии n Количественные (Талассемии) n Качественные, связанные с нарушением структуры цепей гемоглобинов (серповидно-клеточная анемия, анемии, обусловленн носительством нестабильных гемоглобинов и т. д. ) 3. ГА, связанные с нарушением активности ферментов эритроцитов (энзимопатии) n ГА, обусловленные дефицитом активности Г-6 -ФД n ГА, обусловленные дефицитом активности пируваткиназы n ГА, обусловленные дефицитом активностиглютатионредуктазы n

Классификация ГА n 1. 2. 3. 4. n n 2. ПРИОБРЕТЕННЫЕ Гемолитические Анемии ГА, связанные с воздействием АТ(иммунные) Аутоиммунные ГА (АИГА) Болезнь Маркиафавы – Микели (пароксизмальная ночная гемоглобинурия) ГА, связанные с механическим повреждением эритроцитов Механический гемолиз при протезировании сосудов или клапанов сердца Маршевая гемоглобинурия

q. Для АИГА с гемолизинами характерно наличие внутрисосудистого гемолиза (гемоглобинемия, гемоглобинурия и гемосидеринурия). Гемолизины вызывают разрушение эритроцитов в кровяном русле при обязательном взаимодействии с комплементом. АИГА с агглютининами, протекают по механизму внутриклеточного гемолиза.

Клинический случай Анализ периферической крови б-ой К. : WBC – 6, 8 x 109/л, RBC – 1, 97 x 1012/л, Hb – 79 г/л, Ht – 24, 3%, MCV – 123, 4 fl, MCH – 40, 1 пг, MCHC 325 г/л, RDW – 21, 2%, PLT – 303, 0 x 109/л, нормобласты 8 на 100 лейкоцитов, ретикулоциты – 53, 0% n


Клинический случай Больной Б. , 70 лет, поступил в гематологическое отделение в связи с ухудшением самочувствия, прогрессирующей слабостью, потливостью, болями в правом подреберье. В течение 7 лет страдает ХЛЛ. n Объективно: кожные покровы бледные, сухие, печень +2 см, селезенка +3 см, генерализованная лимфаденопатия. n Анализ периферической крови: WBC – 160, 5 x 109/л, RBC – 1, 54 x 1012/л, Hb – 62 г/л, Ht – 22, 3%, MCV – 140, 4 фл, MCH – 40, 1 пг, MCHC 315 г/л, RDW – 23, 2%, PLT – 170, 0 x 109/л, нормобласты 1 на 100 лейкоцитов, ретикулоциты – 28, 0% n

Наследственный овалоцитоз Наследуется по аутосомно- рецессивному типу, Носит нормохромный характер, сопровождается ретикулоцитозом. Овалоциты имеют нормальный средний объем (MCV) и cреднее содержание гемоглобина (MCH). Наибольший диаметр эритроцитов достигает 12 мкм, наименьший - 2 мкм. Овалоциты составляют от 10 до 40 -50% клеток при гетерозиготном носительстве и до 96% эритроцитов при полном носительстве аномальных генов. Осмотическая резистентность понижена, повышен аутогемолиз, COЭ ускорена. Симптоматическая форма овалоцитоза - при гепатитах, миелодиспластическом синдроме и т. д. - исчезает при эффективной терапии основного заболевания. Истинный овалоцитоз - более 10% эритроцитов имеют овальную форму.
Наследственный стоматоцитоз Наследуется по аутосомно- рецессивному типу Периферическая кровь. Морфологическая особенность - стоматоцитоз, который характеризуются наличием в центре клетки неокрашенного участка в виде вытянутой светлой полосы, напоминающей форму рта (Stoma - рот) или округлой формы. Объем эритроцитов и концентрация гемоглобина не отличаются от нормы, Резистентность эритроцитов может быть понижена. В период тяжелых гемолитических кризов снижается концентрация гемоглобина и количество эритроцитов, повышается число ретикулоцитов и содержание неконъюгированного билирубина в сыворотке крови.

Акантоцитоз Наследуется по аутосомно- рецессивному типу, Снижение содержания холестерина, ТГ, ФЛ в крови отражается на липидном составе мембраны эритроцитов, в которой снижена концентрация лецитина, фосфатидилхолина, повышено содержание сфингомиелина, что способствует снижению текучести мембраны и изменению их формы. Эритроциты приобретают зубчатый контур, похожий на листья аканта, Клиника - анемия, симптомы внутриклеточного гемолиза эритроцитов, нарушения обмена липидов (пигментный ретинит, нистагм глаз, тремор рук, атаксическая походка). Анемия - нормохромая. Основной морфологический признак - акантоцитоз (до 40 -80% эритроцитов). Ретикулоцитоз. Осмотическая стойкость эритроцитов нормальная или сниженная. Симптоматический акантоцитоз - при циррозе печени, у пациентов, находящихся на АИК, космонавтов после приземления.

Различают -талассемию и -талассемию: -талассемия – дефект синтеза -цепи (отсутствует м. РНК в гене -цепи глобина). Выделено 4 гена и в зависимости от нарушения, выделяют 4 основные формы -талассемии: гомозиготная -талассемия, Н-гемоглобинопатия, малая -талассемия ( -th 1), бессимптомная форма -талассемии ( -th 2). Картина крови и костного мозга аналогичны -талассемии. -таласемия – отсутствие или нарушение строения -цепи (м. РНК мало или дефектная). Выделяют 2 вида: - гомозиготная – большая таласемия, анемия Кули (тяжелое течение, больные трансфузионнозависимые); - гетерозиготная – малая талассемия (легкая форма, с редкими кризами) Диагностика: высокое содержание Hb. F и Hb. A 2

Картина периферической крови при -талассемии

Благодарю за внимание!
Анемии лекция МПФ.ppt